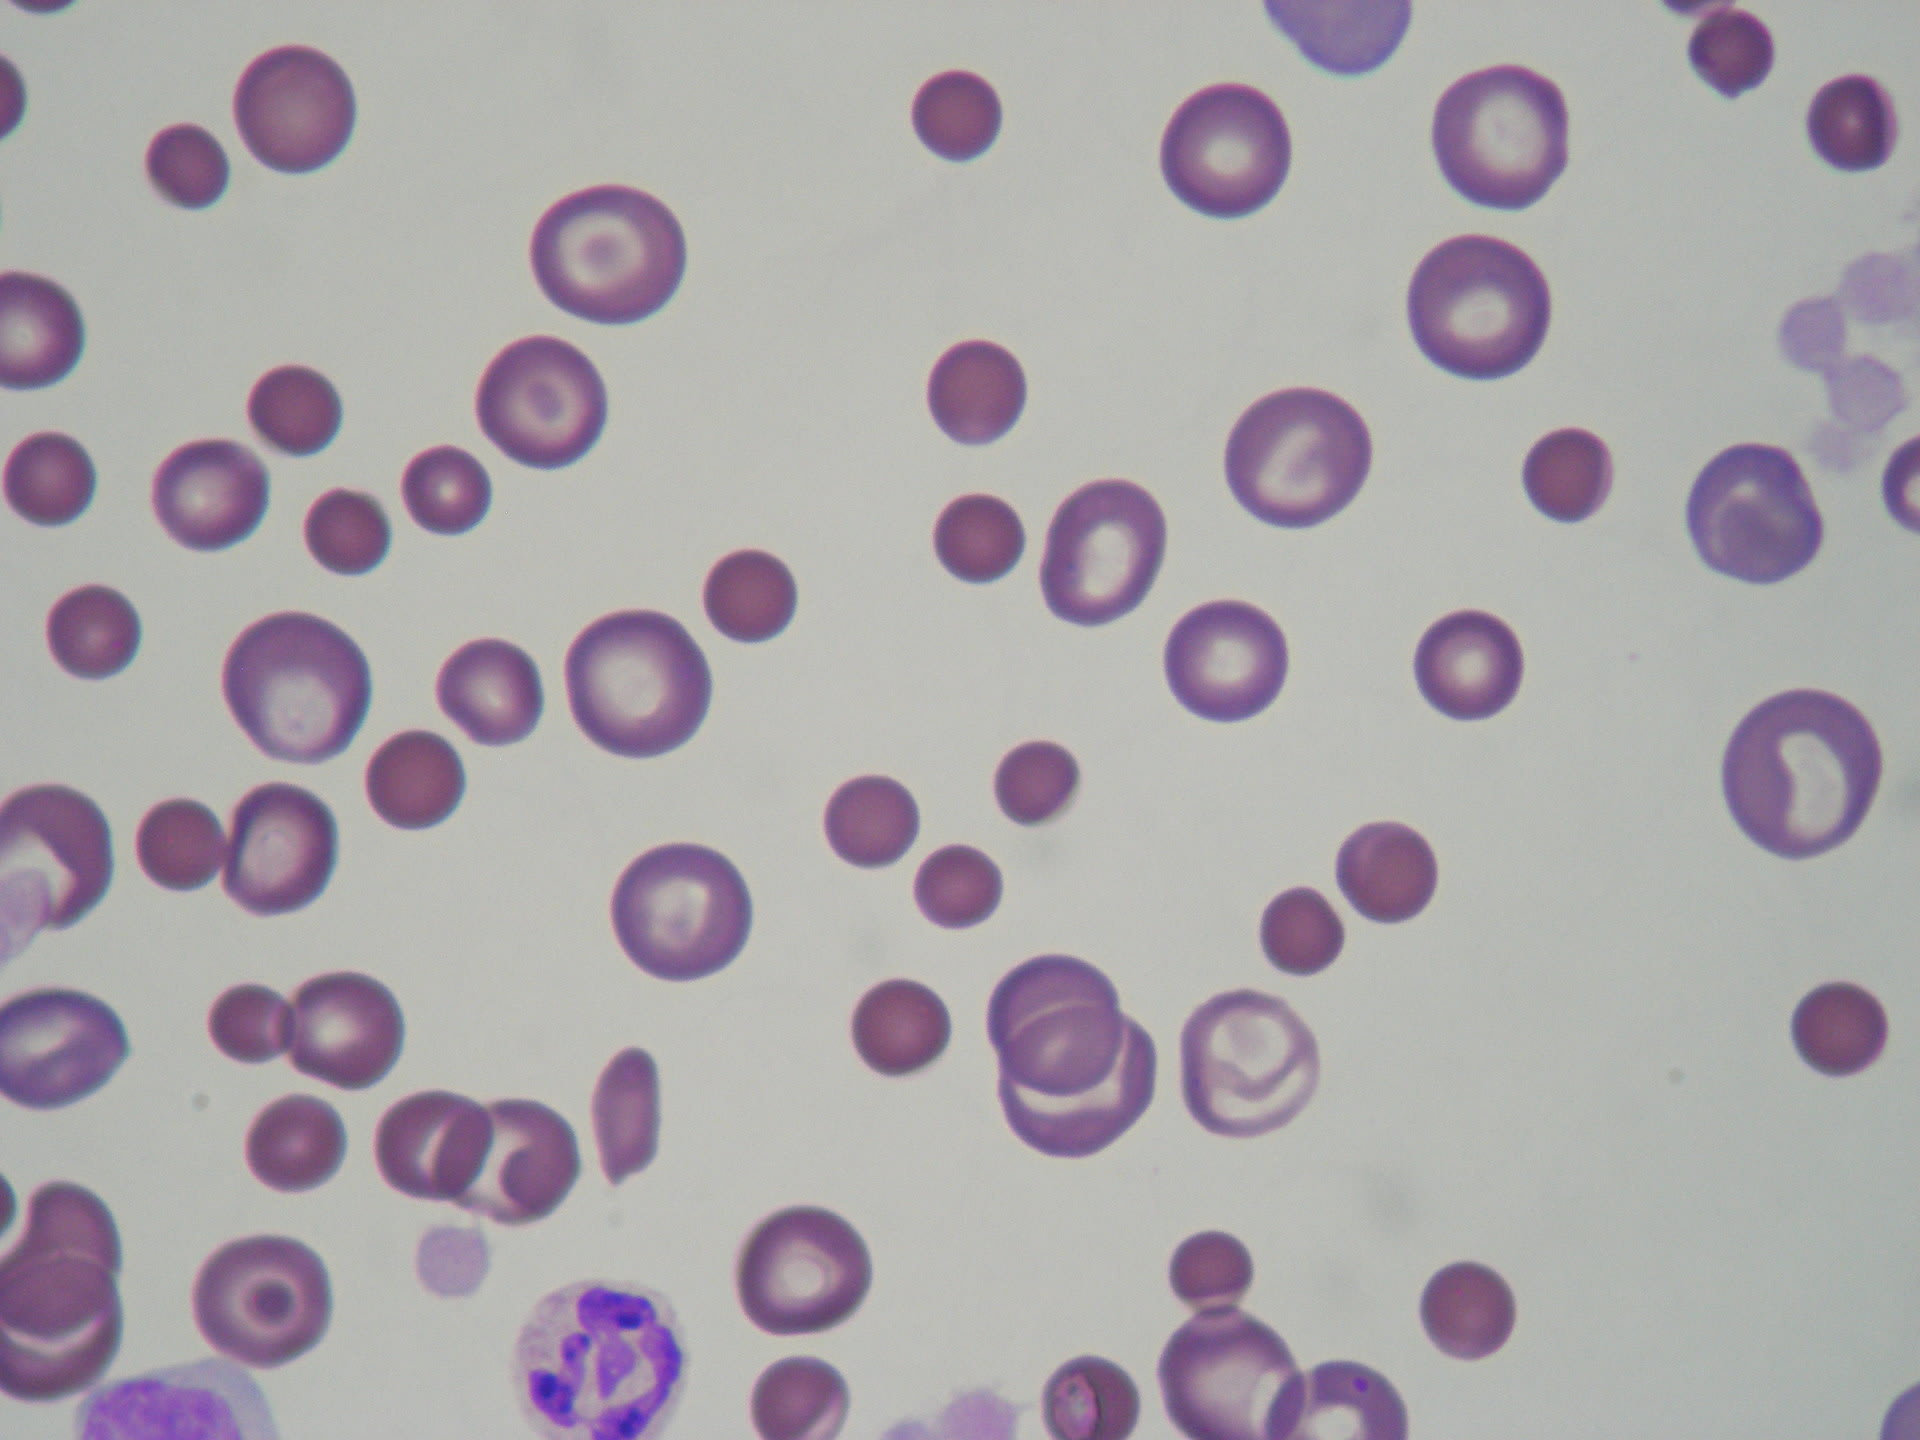
免疫介在性溶血性貧血(IMHA) 王子ペットクリニック 免疫介在性溶血性貧血(IMHA) 王子ペットクリニック

什麼是原發性自體免疫溶血性貧血(AIHA)?. 紅血球會攜帶氧氣至全身進行利用。. 在健康人體內中,紅血球存活約120天。. 但是在自體免疫溶血性貧血 (AIHA) 患者中,免疫系統無法正常運作,且免疫系統破壞紅血球的速度超過製造它們的速度。. 而原發性AIHA是指.. 治療. |. 自己免疫性溶血性貧血は免疫系機能の異常を特徴とする疾患群で、赤血球をまるで異物であるかのように攻撃する自己抗体が生産されます。. 症状がまったくない人もいますし、疲労感や息切れを覚えたり、顔が青白くなったりする人もいます.

免疫介在性溶血性貧血(IMHA) ふく動物病院

PPT 貧血って? PowerPoint Presentation, free download ID506252

貧血の病態をわかりやすく解説!〜Hbとは?巨赤芽球とは?〜

後天性自己免疫性溶血性貧血:症状、原因、診断、治療 ツーZガイド 2024

自分の血液を自分で壊す⁈『IMHA(免疫介在性溶血性貧血)』の怖さとは?①概要・臨床徴候 オタ福の語り部屋

溶血性貧血_遺伝性球状赤血球症、自己免疫性貧血、発作性夜間ヘモグロビン尿症 YouTube

【血液専門医が解説】貧血の症状・診断・治療 【マルイ裏の内科】上野御徒町こころみクリニック|内科・血液内科・糖尿病内科

溶血性貧血の分類 東京女子医科大学病院 輸血・細胞プロセシング部

112F39 動画で学ぶ医師国試(MAC)温式自己免疫性溶血性貧血について(今日の1問) YouTube
免疫介在性溶血性貧血(IMHA) 王子ペットクリニック

貧血の病態をわかりやすく解説!〜Hbとは?巨赤芽球とは?〜
_0.png)
免疫介在性溶血性貧血(IMHA) <猫> みんなのどうぶつ病気大百科

自己免疫性溶血性貧血AIHAの特徴と温式冷式の抗体血管内or外溶血の覚え方・ゴロ ゴロゴロ医学

なんとあれを使うと自己免疫性溶血性貧血を発症するのです 特発性血小板減少症と自己免疫性好中球減少症と原因は同じです YouTube

自己免疫性溶血性貧血の検査 福山臨床検査センター

自身免疫性溶血性贫血,要点总结! 知乎

貧血の種類|検査値(Hb,MCV)での見分け方と原因疾患 ぴんころ

PPT 貧血って? PowerPoint Presentation, free download ID506252

自己免疫性溶血性貧血どんな病気?検査や治療は?完治できるの? 株式会社プレシジョン
![治療抵抗性の自己免疫性溶血性貧血と診断されていた特発性寒冷凝集素症[難渋症例から学ぶ診療のエッセンス(95)]|Web医事新報日本医事新報社 治療抵抗性の自己免疫性溶血性貧血と診断されていた特発性寒冷凝集素症[難渋症例から学ぶ診療のエッセンス(95)]|Web医事新報日本医事新報社](https://www.jmedj.co.jp/files/product/jrnl/5052/5052_010_05.jpg)
治療抵抗性の自己免疫性溶血性貧血と診断されていた特発性寒冷凝集素症[難渋症例から学ぶ診療のエッセンス(95)]|Web医事新報日本医事新報社
自己免疫 性溶血性貧血は,自己抗体と赤血球が最もよく結合する温度 (至適温度)によって温式と冷式に分類される。冷式はさらに, 寒冷凝集素症(CAD)とDonath Landsteiner抗体が検 出される発作性寒冷ヘモグロビン尿症(PCH)にわけられる。温. 3. 同種免疫性溶血性貧血(不適合輸血、新生児溶血性疾患)および薬剤起因性免疫性溶血性貧血を除 外する。 4.1.~3.によって診断するが、さらに抗赤血球自己抗体の反応至適温度によって、温式(37℃)の 1)と、冷式(4℃)の2)および3)に区分する。